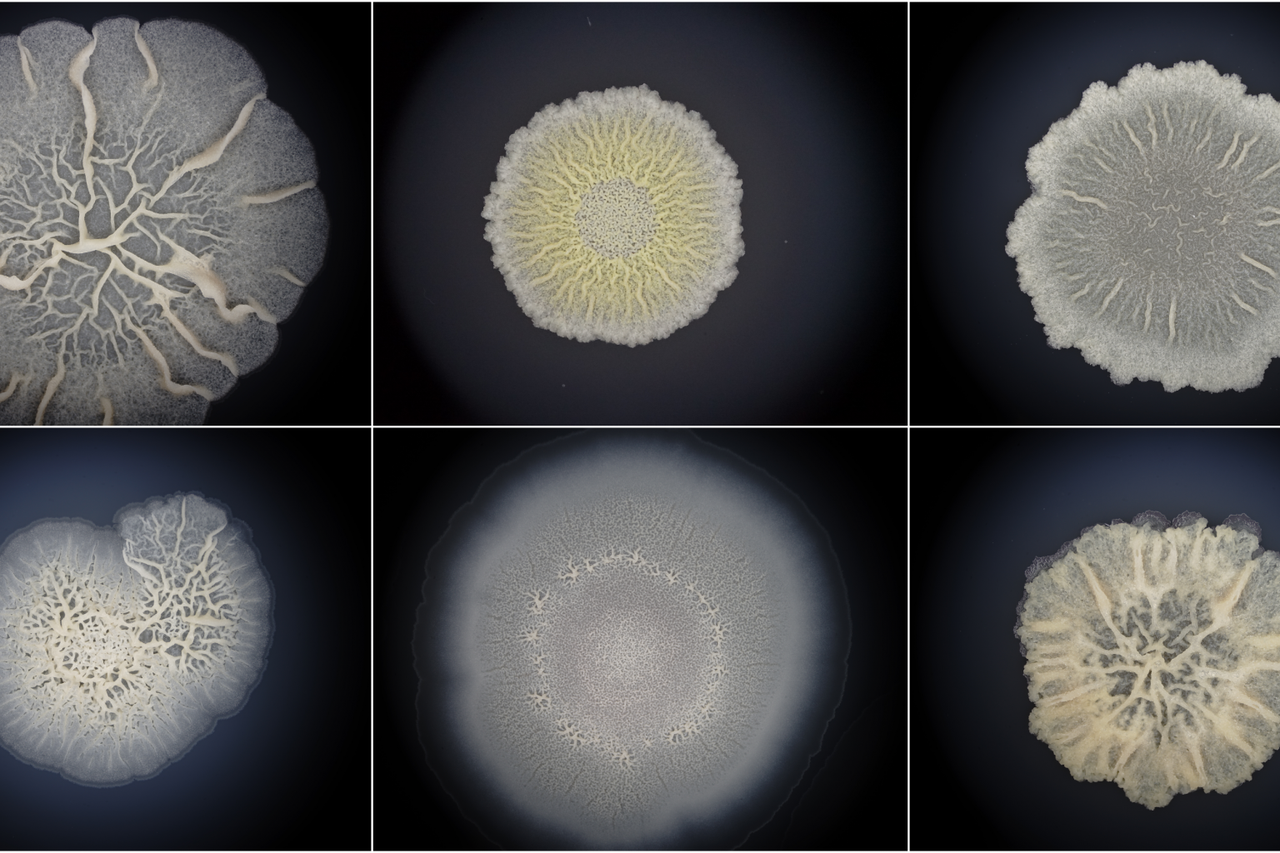

Video sadržaj
14
prvi oblici života na Zemlji
Veliko otkriće znanstvenika s Ruđera: Ovo baca novo svjetlo na spoznaje o evoluciji!
Najnoviji rezultati istraživanja bakterijskih biofilmova donose nove spoznaje o prvim oblicima života na zemlji
